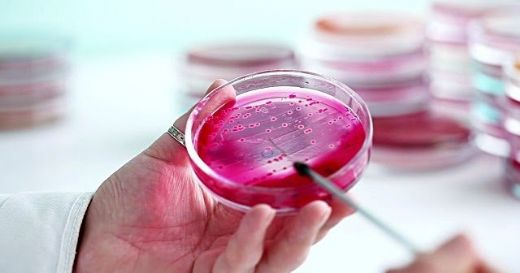
Ferritin Nasıl Yükseltilir?

Ferritin Nasıl Yükseltilir?
Ferritin, vücutta demiri depolayan ve düzenleyen bir protein kompleksidir. Ferritin seviyeleri, demir durumu hakkında bilgi verirken, düşük seviyeler demir eksikliğine, yüksek seviyeler ise inflamatuar hastalıklara işaret edebilir. Ferritin seviyelerini artırmak için demir takviyeleri, demir açısından zengin gıdalar ve sağlıklı beslenme önerilmektedir.
Ferritin Nedir?Ferritin, vücutta demir depolayan ve düzenleyen bir protein kompleksidir. Vücutta bulunan demirin büyük bir kısmı ferritin moleküllerinde depolanır. Ferritin, hem hücre içindeki demirin kullanımı için bir kaynak sağlar hem de demirin aşırı birikimini önleyerek toksik etkinin azaltılmasına yardımcı olur. Ferritin seviyeleri, vücuttaki demir durumunu yansıtmakta önemli bir biyomarker olarak kabul edilir. Düşük ferritin seviyeleri, demir eksikliği anemisi gibi durumların habercisi olabilirken, yüksek ferritin seviyeleri, enflamatuar hastalıklar veya demir yüklenmesi gibi durumları gösterebilir. Ferritin Yükseltme Yöntemleri Ferritin seviyelerini yükseltmek için çeşitli yöntemler mevcuttur. Bu yöntemler, bireyin genel sağlık durumu, beslenme alışkanlıkları ve mevcut tıbbi sorunlara göre değişiklik gösterebilir. Aşağıda ferritin seviyelerini artırmaya yönelik bazı etkili yöntemler sıralanmıştır:
Ferritin Yükseltme Sürecinde Dikkat Edilmesi Gerekenler Ferritin seviyelerini artırmak amacıyla uygulanan yöntemler, dikkatli bir şekilde değerlendirilmelidir. Aşağıdaki hususlar göz önünde bulundurulmalıdır:
Sonuç Ferritin seviyelerinin artırılması, demir eksikliği ve ilgili sağlık sorunlarının önlenmesi açısından büyük önem taşımaktadır. Yukarıda belirtilen yöntemler ve öneriler, ferritin seviyelerini yükseltmek için kullanılabilir. Ancak, bu süreçte sağlık profesyonellerinin rehberliği ve önerilerine uyulması kritik öneme sahiptir. Sağlıklı bir yaşam tarzı benimsemek, ferritin seviyelerini doğal yollarla artırmak için etkili bir strateji olabilir. Ekstra Bilgiler - Ferritin seviyeleri, kan testleri ile ölçülmektedir. Normal ferritin seviyeleri, yaş ve cinsiyete bağlı olarak değişiklik gösterebilir.- Aşırı ferritin birikimi, genetik faktörler, aşırı demir alımı veya bazı hastalıklar nedeniyle gelişebilir. Bu durum, sağlık sorunlarına yol açabileceği için dikkatle izlenmelidir.- Düzenli sağlık kontrolleri, ferritin seviyelerinin izlenmesi ve gerekli önlemlerin alınması için önemlidir. |

Ferritin eksikliği yaşayan biri olarak, neden bu kadar fazla yorgun hissediyorum? Ayrıca, adet dönemlerimde aşırı kan kaybı yaşıyorum; bu durum ferritin seviyemi nasıl etkiliyor? Hangi demir bakımından zengin besinleri tüketerek ferritin değerlerimi yükselterek anemi riskini azaltabilirim?
Durkadın, ferritin eksikliği yaşıyorsanız, bu durum vücudunuzun yeterince demir depolamadığı anlamına gelir ve bu da yorgunluk hissine neden olabilir. Demir, kırmızı kan hücrelerinin üretiminde önemli bir rol oynar ve bu hücreler oksijeni vücudunuzun dokularına taşır. Yeterli demir olmadan, vücudunuz yeterli oksijen taşıyamaz, bu da yorgunluk ve halsizlik hissine yol açar.
Adet dönemlerinizde aşırı kan kaybı yaşıyorsanız, bu durum vücudunuzun demir depolarını daha hızlı tüketmesine neden olabilir. Fazla kan kaybı, demir eksikliğine ve dolayısıyla düşük ferritin seviyelerine yol açar, bu da anemi riskinizi artırır.
Ferritin seviyelerinizi yükseltmek ve anemi riskini azaltmak için demir açısından zengin besinler tüketebilirsiniz. Önerilen besinler arasında kırmızı et, tavuk, balık, ıspanak, brokoli, mercimek, nohut ve fasulye gibi baklagiller bulunur. Ayrıca, C vitamini içeren besinler (örneğin portakal, çilek, kivi) demirin emilimini artırabilir, bu yüzden demir açısından zengin bir öğünle birlikte C vitamini de tüketmeye özen gösterebilirsiniz.